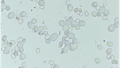

はじめに
牛って、ずっともしゃもしゃしているイメージがありませんか?
実はその「食べ方」を支えているのが、とても特徴的な歯の構造なんです。
⇧もしゃもしゃの様子(タップすると動画が再生されます)
以前のブログでも少し触れましたが、今回は牛の歯をもう一歩深く見ていきます。
過去ブログ⇩
牛の歯の基本(復習編)

牛の歯は、大きく分けて2つの役割があります。
・前歯(切歯):草をちぎる
・奥歯(臼歯):すり潰す
ただし…牛の上あごには前歯がない!んです。

それぞれの歯は、歯冠、歯頸、歯根の各部に分けられ、表面上見えているのは歯冠の部分までになります。そしてそれらの歯はゾウゲ質、エナメル質、セメント質により構成されています。そして人間と大きく違う点は、牛は前歯と奥歯の間に歯がない部分があるということです。
ちなみに、画像の中の牛ちゃんは、下の前歯が一本欠けてしまっていました。(画像左から3番目)採食には問題なさそうでしたが、人間も牛も歯は大事にしないといけませんね…
上顎の秘密

牛は上あごに歯がない代わりに、「歯床板(ししょうばん)」という硬い歯茎が存在しています。草を食べるときは下の歯+歯床板で挟んで引きちぎっています。つまり、牛の食べ方は「噛み切る」ではなく「引きちぎる」スタイルなんです。これは草を効率よく食べるための進化と言われています。そして奥歯はとても発達していて、横にすり潰す動きが得意です。
他の動物と比較
他の動物はどうでしょうか。
牛→・上の前歯なし・すり潰しに特化している・反芻をする
馬→・上下に前歯あり・草を「噛み切る」・反芻はしない
犬→・肉を裂く歯(裂肉歯)・咀嚼より「飲み込む」に近い
と、このように、動物種・食べるものの種類によって歯の構造が変化していることがわかります。
さらに、牛と同じように上顎に前歯がない動物にはヒツジやヤギ、シカなどの反芻動物が該当します。他にも、ラクダは一部上顎に前歯があるそうですが、牛と似たような口腔構造をしているそうです。
まとめ
牛の歯は、「草を食べること」に特化したとても合理的な構造をしていました。生きるためにもっとも重要なことの一つ、「採食」を支えている歯を学ぶことで、牛の健康をもっと支えることができるかもしれませんね。
⇧咀嚼する牛(タップすると動画が再生されます)
次回は歯についてのミニコラムをご紹介します。今回もありがとうございました!

コメント